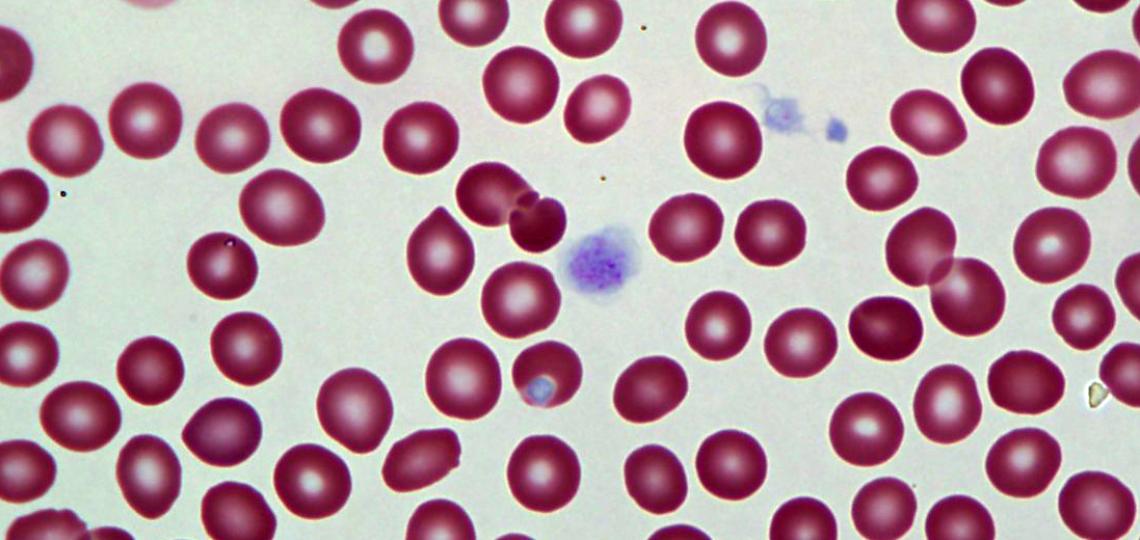
A blood smear sample showcasing giant platelets.

About the Program
Number of Positions: Two positions per year
Length: 1-year fellowship
The Hematopathology Fellowship Program at Baylor College of Medicine has been in existence since July 1, 1987. Since the start of the fellowship we have trained multiple fellows with diverse interests (academic, research, clinical). The philosophy of our Hematopathology fellowship program is to provide broad exposure to the evaluation of hematopathological diseases and to the technology that can be utilized to diagnose hematologic disorders correctly. Of note, being present in the world’s largest medical center, our fellows get to take advantage of the other excellent institutions being present in the vicinity (see example of the rotation schedule). To point out a unique feature is the dedicated rotation in a pediatric hospital, which helps educate and familiarize our fellows with the pediatric hematologic disorders, such as Inherited bone marrow failure syndromes, refractory cytopenias of childhood etc. Our past fellows have gone on to practice in diverse areas, such as academic positions, private practice groups, or into additional fellowships such as cytopathology, surgical pathology, pediatric pathology, and molecular genetic pathology.
Learn more about the program curriculum and how to apply for the program.
Stipends and Benefits
Visit our BCM Trainees Resource Page to learn more stipends and benefits available for pathology fellows.
Admissions
Candidates must have satisfactorily completed the training required for certification in clinical and/or anatomical pathology by the American Board of Pathology. At the discretion of the department chair and the program director, board-certified or board-eligible physicians in related specialties may be considered for appointment.
All application materials, including recommendation letters, must be submitted online and include the following:
- Completed online House Staff Application
- Current Curriculum Vitae
- Personal Statement
- USMLE/COMLEX Transcripts
- Two Recommendation Letters (one from Program Director)
Applications are accepted July 1 – Sept. 30 for the position that starts July 1 the following year.
Interviews are offered beginning mid-August and completed by the end of November.
Curriculum
Fellows are exposed to a broad range of both benign and malignant pediatric and adult hematopathology as well as the ancillary diagnostic testing in the diagnosis of those disorders.
All rotations occur in the Department of Pathology & Immunology and the Clinical Laboratories therein. Rotations include:
- Ben Taub Hospital, Hematopathology service, 18 weeks
- Texas Children's Hospital, Hematopathology service, 12 weeks
- Texas Children's Hospital, Coagulation service, 2 weeks
- Texas Children's Hospital, Molecular genetics & cytogenetics, 4 weeks
- Texas Children's Hospital, Lab management & hemoglobinopathies, 2 weeks
- Texas Children's Hospital, Lab automation & flow cytometry, 2 weeks
- Baylor St. Luke’s Medical Center, Hematopathology service, 4 weeks
- Methodist Hospital, Bone marrow, lymph node, and flow cytometry services, 4 weeks
- MD Anderson Cancer Center, Flow cytometry service, 4 weeks
View an example of a fellow’s schedule.
Note: A hematopathology fellow has 3 weeks vacation time and can take vacation days during any time frame, but with approval of the site rotation director. The fellow is also instructed to inform about vacation 2 weeks in advance.
Being a one year fellowship and multiple sites of rotations, an elective rotation or dedicated research rotation cannot be scheduled. Also, being a pathology subspecialty, the fellows do not rotate in direct patient care; the training encompasses review of smears, slides, laboratory data etc.
Fellows are encouraged to participate in departmental conferences for pathology residents and fellows, and a variety of conferences based at individual hospitals. Conferences include:
- WHO Review (weekly)
- Journal Club (monthly)
- Citywide hematology conference (weekly)
- Citywide hematopathology conference (monthly)
- Lymphoma histology review (monthly)
- Hematopathology journal club (monthly)
- Leukemia journal club (twice a month, Texas Children's Hospital only)
All teaching faculty participate in a variety of primarily clinical and translational research projects. Opportunities abound both within the Department of Pathology & Immunology as well as potential collaborations with other clinical departments or faculty at other institutions within the Texas Medical Center. Fellows are expected to participate in supervised research.
Contact Us
Interested applicants should address communications to Program Director, Dr. Tarek M. Elghetany, and Program Coordinator, Rosario Guzman.
Life in Houston
Houston, the nation's fourth largest and most diverse city, offers all the benefits of a big city at a significantly lower cost of living than other major cities.